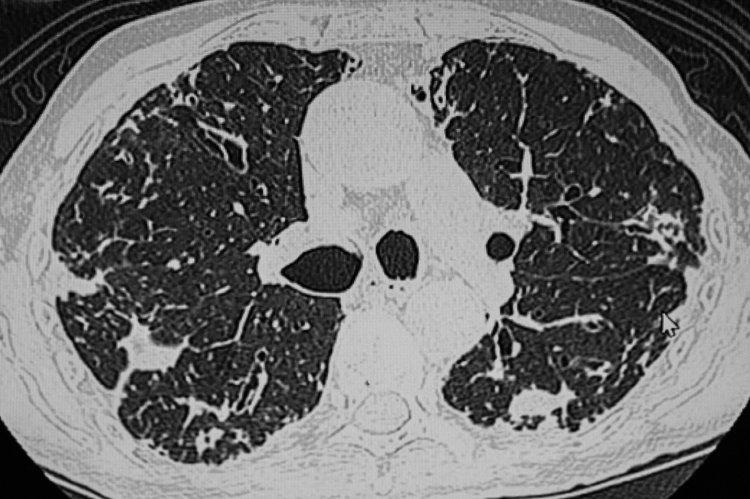

連喫1個月,結節突然瘋長!醫生提醒:這4種食物是結節“催化劑”
你有定期體檢的習慣嗎?在體檢報告裏是否有出現結節字樣?
有調查發現,我國有甲狀腺結節的羣體數量高達2億,其中有70%爲女性。且10個女性里約有8個有甲狀腺結節、乳腺增生。
生活中大家對於結節的態度呈2個極端,有些人一聽就驚慌失措、急於“散結”,有些人則覺得不疼就無關緊要。那查出結節後到底該怎麼應對呢?

一、喫不對,真的會“養大”結節!
李阿姨今年59歲,乳腺內的結節和她和平共處了近20年時間。但在去年冬天,她體內的結節突然迅速變大。那會天氣剛冷,她想着冬天是進補的好時機,每天都會服用阿膠、蜂王漿、雪蛤湯來溫補,喫了不到一個月時間就感覺乳房內脹痛。
去醫院一查,原先的結節從5 mm長到了18 mm,且邊界十分不清晰,有很大的惡變風險,醫生建議她手術切除。
這讓李阿姨覺得特別奇怪,體內這個結節好多年了,怎麼突然有惡化趨勢。瞭解過往史後,醫生認爲與她盲目進補有很大關係。
乳腺是對激素很敏感的奇怪,李阿姨大量食用的阿膠、蜂王漿等滋補品內有天然、類雌激素成分,會打破體內激素平衡,讓結節快速生長。

對於體內有結節的人來說,雖然沒有絕對的飲食禁忌清單,但減少或避免以下四類可能“助長”結節的食物,也是一種審慎的自我保護策略:
1、含碘量高的食物
對於有甲狀腺結節或是伴有甲亢的患者來說,甲狀腺對於碘的生物利用率較高,攝入大量含碘量高的食物容易加重病情。
2、部分海鮮
如蝦、生蠔、鯉魚等嘌呤含量高的海鮮,進入體內後會代謝產生尿酸,尿酸水平過高容易讓身體代謝障礙,誘發相關的疾病發生。

3、含激素的食物
過量的激素攝入容易導致體內內分泌紊亂,還可能會促進結節生長。尤其是甲狀腺結節、乳腺結節這類與內源性激素關聯大的問題,一定要少喫激素含量豐富的食物。
4、熱性食物
如茴香、香菜、大蒜、生薑、辣椒等食物,進入體內會產熱,大量攝入會給身體帶來很強的刺激性,促進結節發展。

二、結節究竟是什麼?會發展成癌嗎?
從中醫角度來看,體內新長出來與正常組織不同的東西就是“結”,如胃腸道息肉、血管斑塊、火癤子等。還有胃腸脹氣、鼓包等無形的積聚,在中醫概念裏也屬於“結”。
西醫認爲的結節則一般是指乳腺結節、甲狀腺結節、肺結節。那麼,結節會不會癌變?這是所有人最關心的問題。
針對最常見的三種結節,小九跟大家好好聊聊:

- 肺結節
肺結節是指肺部出現的≥3cm的病竈,在影像學裏表現爲密度增高的陰影。
中國醫學科學院腫瘤醫院山西醫院胸外科主任廉建紅指出,現在檢查儀器的精密度都很高,一些微小結節也能被及時發現,這些結節發現時大部分是比較早期的,無需過分緊張。尤其是8mm以下的結節,一般都建議以隨訪爲主。
建議年齡>45歲的成年人每年進行一次肺部CT檢查,通過檢查可及時發現早期潛在的問題,對防治結節有重要意義。
- 乳腺結節
乳腺結節一般是指乳腺組織內的良性表現,在育齡期女性身上十分多見,檢出率高達25.68%。
中國醫學科學院腫瘤醫院山西醫院乳腺外科主任齊立強表示,乳腺結節的檢出率很高,但發展成癌的比例很小,可能100個人裏面只有1個或不到1個,不用過於恐慌。
40歲以上的女性要每年進行一次乳腺彩超,每2年進行一次乳腺鉬靶檢查。

- 甲狀腺結節
甲狀腺結節是指甲狀腺組織內出現的侷限性腫塊,會隨着吞嚥動作上下移動。
中國醫學科學院腫瘤醫院山西醫院頭頸外科主任李德志表示,B超檢查中有20~30%的人會檢出大小不一的甲狀腺結節,大部分爲良性,最終診斷爲惡性的概率僅有3~4%。但還是建議普通人每年進行一次甲狀腺檢查。
在發現結節後,要及時找一位專業的醫生判斷良惡性,之後再遵醫囑是進行治療還是隨訪。

三、真的存在“結節體質”嗎?
結節的發生與日常的生活習慣有很大關係,如果你身上有這些壞習慣的話,很可能把自己養成“結節體質”。
1、喫得油膩
過於油膩的飲食進入體內後難以及時消化,會損傷脾胃,導致水谷精微無法正常運轉,最終會形成痰溼,而痰溼很容易形成結節。
2、缺乏鍛鍊
長期缺乏運動會導致氣血虛弱,體內血液循環不暢、水液運化失調,從而導致痰濁、痰血滯留在體內,形成結節。

3、情緒不穩定
中醫認爲,結節的發生與情緒有很大關係。長期情緒不好會導致肝氣鬱結,而肝氣鬱結會讓體內氣血循環受阻,產生大量的痰、邪、液等物質,最終形成結節。
4、愛熬夜
熬夜會讓體內的各個臟器也無法得到休息,其中也包括甲狀腺。而甲狀腺長期過勞,會影響到正常的激素分泌,讓其功能下降產生代償反應,結節也會逐漸變大。

在體檢中發現結節無需過分緊張,但也要遵醫囑定期隨訪,保持良好的生活習慣,儘可能避免讓結節持續發展。
參考資料:
[1] 《體內有結節的人,儘量少喫這4種“發物”,別讓嘴饞害了你》.DrX說2024-04-11
[2] 《體檢查出結節,必須切除?關於結節,醫生這樣回答→》.科普中國2023-04-23
[3] 《你習以爲常的6個行爲,正在加速結節生長!很多人忽視了》.人民日報健康客戶端2025-07-01

















